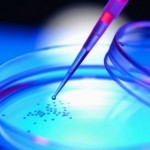

di Vittorio Sammarco
Cosa ci insegna il caso Stamina, al di là delle immediate implicazioni giudiziarie ed etiche? Tante cose, forse troppe, che esprimono lo stato confusionale nel quale la nostra società contemporanea versa e si dibatte, e la difficoltà di darle un senso un ordine, una coerenza nelle direzioni da prendere.
Il rinvio a giudizio del signor Vannoni, laureato in Psicologia che ha inventato, diffuso – e venduto, nonostante le sue plurime smentite, a caro prezzo, come testimoniano i pazienti – un presunto farmaco che prometteva di guarire “centinaia di malattie”, non è una faccenda che riguarda solo i parenti dei malati e gli addetti ai lavori di cura (medici, sanitari, dirigenti, industriali farmaceutici e istituzioni del settore).
Riguarda tutti perché centra al cuore il nucleo portante della società moderna che – fra le tante cose nefaste che produce – almeno su un principio, di certo, possiamo concordare, ha costruito la sua forza: la sapienza vale più dell’ignoranza. Su questo possiamo essere d’accordo? E se poi lo applichiamo nella scienza, che ha delle ricadute dirette nella tecnica con cui abbiamo a che fare ogni giorno, ebbene, quel principio vuol dire: se conosco bene le cose, i fenomeni, gli eventi, gli elementi della natura e le dinamiche con cui interagiscono, posso ricavarne vantaggi, posso stare meglio. Io e chi sta con me.
Ma questa capacità di conoscere segue delle regole, delle procedure, che l’esperienza di anni di ricerca hanno maturate e sedimentato in un sapere collettivo, tramandato di generazione in generazione a beneficio di tutti. Qualcuno (vedi l’industria farmaceutica) avrà anche fatto degli affari, ma l’aspettativa di vita media si è allungata e molte malattie debellate.
Per far sì che questo sistema fosse consolidato – proprio per evitare truffe ed errori a danno dei più deboli – sono stati studiati e realizzati negli anni gli istituti di ricerca, i modelli per garantirne il corretto operato e i protocolli (internazionali) di ricerca per autenticarne capacità ed efficacia.
Ecco, tutto questo ormai sembra essere crollato sotto i colpi della medicina fai da tè e dei loro sostenitori. La sapienza (la conoscenza) con tutto ciò che ne deriva non è patrimonio di chi ha faticosamente imparato prima, sperimentato poi, e comprovato durante. Tutto ciò ha ormai preso l’odore dello snob (del “professorone”), di colui che, non si sa come, ha conquistato una fetta di potere e vuole conservarla per ricavarne un lucro. E così chiunque può dire quello che vuole e criticare, amplificato da un clic che si reitera e circola – guarda un po’ – in maniera “virale”. Distruggendo quelle convinzioni che – a beneficio di tutti – avevano consolidato delle certezze su cui potevamo progredire.
E’ proprio questo il punto che ci riguarda tutti: la decisa destrutturazione e scomposizione di ogni principio di autorevolezza, in particolare quella scientifica. La gerarchia di valori che un tempo, in maniera verticale, quantomeno garantiva un principio di referenzialità responsabile (di pensieri e azioni), ha lasciato il passo ad un’orizzontalità in cui tutti – sullo stesso piano – hanno “legittimità” di pensiero e azione. Non è tanto un relativismo etico. E’ l’attacco al cuore della modernità, della laicità che fonda sul merito comprovato e riconosciuto e non su altro (appartenenza, fideismo, superstizione, appeal,…) la propria credibilità.
Ora, so bene che il dolore dei parenti e dei malati, schiacciati dalla sofferenza e dalla fragilità di una scienza che non sempre ha una soluzione per tutto (e che invece viene spesso confusa con un mercato di nuovi prodotti sempre in grado di presentare le magnifiche sorti e progressive a portata di carta bancomat), quel dolore ha consentito a Vannoni e ai suoi adepti (non so come chiamare quei professionisti che si sono fatti convincere dalla bontà del metodo…) di affermare con ardore che il metodo andava sostenuto fino a invocare l’intervento economico dello Stato, nonostante le ombre e i dubbi palesati da molte persone oneste (si vedano le posizioni pacate e ragionevoli della scienziata e senatrice Elena Cattaneo).
Quelle sofferenze, non solo non vanno trascurate, ma neppure criticate: il male rende meno prudenti e più disposti a non chiudere nessuna porta.
Ma quelle trasmissioni televisive, quegli articoli, quei giornalisti che non hanno fatto il loro dovere e – anzi – hanno detto che dietro gli ostacoli a Vannoni c’era l’interesse del profitto di chissacchì, ecco, quel sistema mediatico di sostegno (non tutti, meno male, la Stampa e il Sole24ore si sono salvati con coraggio prima che Guariniello arrivasse alla conclusione della sua inchiesta), ebbene dovrebbe interrogare noi tutti che facciamo questo mestiere. E anche i semplici utenti.
Era già successo (vedi caso Di Bella) e forse succederà ancora. Basta aspettare la prossima falsa notizia su una scoperta eclatante per riattivare il perverso meccanismo. Eppure su questa situazione non possiamo e non dobbiamo adagiarci.
Perché la certezza della scienza e della ricerca (e delle sue ricadute tecnico pratiche) è cruciale per la nostra vita quotidiana. Come lo è la certezza del diritto per la vita civile; la certezza della trasparenza nella gestione dei partiti per la vita politica; la certezza nella corretta concorrenza delle forze economiche e così via.
Ecco: la certezza. Questa risorsa, quanto mai scarsa in tempi di assolutizzazione dell’individuo capace di mettere in discussione tutto e tutti, nell’ansia distruttiva generata dalla scelleratezza di alcuni (molti?) di assumere posizioni di potere svincolati da qualche responsabilità, ma poi incapace essa stessa di costruire nuovi sistemi di convivenza sociale e civile, deve tornare ad essere obiettivo e fondamento perseguito da tutti e in tutti i campi.
C’è da lavorare molto e con costanza, ognuno nei propri settori di appartenenza e lavoro. Quello dell’Informazione corretta è uno di questi, non oso dire il più importante (ma ci vado vicino…). E lasciamo da parte la distinzione fra vecchi e nuovi media, il flusso ormai è unico.
Bisogna avere coraggio e agire con forza. L’associazione dei giornalisti cattolici l’Ucsi, per esempio, lo sta facendo non avendo timore di chiamare in causa l’etica per un Osservatorio sui Media che ridia spessore e orizzonte al nostro lavoro. Auguri.
Così Scienza, Medicina, Magistratura, Industria, Commercio, Chiesa, Insegnamento, e – manco a dirlo – Politica, devono – ne abbiamo assoluto bisogno – intraprendere un percorso di responsabilità che ridia speranza e solidità ad una società che ha sì introdotto grandi dosi di trasparenza e democrazia, ma che rischia di perdersi nel flusso magmatico dove, sì, forse “uno conta uno”. Ma è ancora più probabile che, alla fine, nessuno conti più nulla.